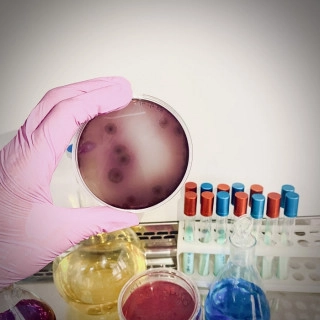

Данная организация находится в статусе «Архивная» — это означает, что с последнего её посещения под управляющим аккаунтом прошло более 365 дней.
Как такое могло произойти?
- был утерян доступ (логин/пароль) к управляющему аккаунту;
- был утерян доступ к привязанной почте;
- сотрудник вашей организации, который добавил организацию, более не работает в вашей организации.
В соответствии с правилами SciNetwork такие организации переводятся в статус «Архивная», а на её странице располагается данный информационный блок, чтобы дать возможность представителям организации восстановить доступ.
В марте 2022 года в богатой палитре научных учреждений Роспотребнадзора появился новый институт – Научно-исследовательский институт системной биологии и медицины (НИИ СБМ).
Целью вновь организованного Института является проведение фундаментальных исследований и получение практических результатов для обеспечения адекватных мероприятий по контролю за распространением инфекционных агентов, их молекулярная характеристика, выявление продуктов синтетической биологии, неблагоприятных для существования человека, и создание отечественных прототипов микро- и нанороботов для диагностики состояния человеческого организма в эпоху цифровой экономики.
Созданный на базе одного из старейших институтов Службы – НИИ дезинфектологии, – новый институт будет развивать одно из наиболее актуальных на сегодня направлений научной деятельности своего предшественника – борьбу с инфекциями.
Сотрудники Института активно включились в исследование новой коронавирусной инфекции, вызванной вирусом SARS-CoV-2: в геномном центре, оснащенным самым современным оборудованием, проводится полногеномное секвенирование образцов геномов возбудителя COVID-19 – до 2000 образцов в неделю.
Невозможно предсказать, с какими еще ранее неизвестными вирусами придется встретиться человечеству. Поэтому в списке приоритетных задач – изучение механизмов взаимодействия патоген–хозяин для разработки методов быстрого обнаружения иммуногенных частей возбудителя и определения протективных (защитных) антигенов для конструирования средств иммунопрофилактики (вакцин нового поколения, моноклональных антител). Работы в этом направлении позволят ускорить процесс разработки и создания вакцин против новых вирусов в самые сжатые сроки, как это предусмотрено концепцией «Санитарного щита».
Специалистами НИИ СБМ будет проводиться системное изучение параметров нормальной жизнедеятельности человека, развитие идеологии и практических методов определения здоровья здорового человека, разработка новых методов оценки биологического возраста и определение эффективности воздействия различных профилактических процедур на здоровье. Институт будет специализироваться на молекулярно-генетических технологиях оценки нормального статуса и ресурса здоровья, а также проведении на их основе комплекса мероприятий для коррекции и восстановления здоровья.
Данное направление неразрывно связано с необходимостью разработки нового класса диагностических приборов - миниатюрных биосовместимых устройств, которые позволят в режиме реального времени отслеживать изменения различных параметров здоровья и соотносить их с индивидуальной нормой пациента. Такие приборы должны быть пригодны для домашнего применения и быть совместимы с уже привычными нам всем гаджетами: смартфонами, планшетами, персональными компьютерами, чтобы передавать информацию о здоровье пациента лечащему врачу в режиме реального времени.
Еще одним важным аспектом работы станет изучение закономерностей, способствующих или препятствующих распространению устойчивости к антибиотикам с последующей разработкой средств быстрого реагирования. Эта проблема приобретает особую актуальность, особенно на фоне ожидаемого роста антибиотикорезистентности как последствия пандемии COVID-19.
Институт оснащен высокопроизводительными системами определения структуры геномов возбудителей вирусной и бактериальной природы, а также анализа метагеномных данных для выявления ассоциированных патогенов масс-спектрометрическим и другим аналитическим оборудованием, которое позволяет использовать многопараметрические методы чтения биологических текстов и определять их свойства.
Создание подобных учреждений приобретает особую значимость в контексте реализации правительственной инициативы «Санитарный щит». Инициатива направлена на укрепление и модернизацию всей системы санитарно-эпидемиологического надзора, включая лабораторную инфраструктуру. НИИ СБМ станет важным структурным элементом «Санитарного щита», принимая активное участие во внедрении новейших методов анализа в работу подведомственных учреждений, интеграции и анализе получаемых данных, а также в создании отечественных методов анализа и их внедрении в практику.
Новый Институт – компактная, самодостаточная и эффективно работающая структура, в штатном составе которой 1 академик и 2 члена-корреспондента РАН, 5 докторов наук, 21 кандидат наук. Это молекулярные биологи и химики, генетики и математики, биоинформатики и аналитики. Подавляющее большинство – молодые ученые в возрасте 27–40 лет. Возглавляет Институт доктор биологических наук, профессор, академик РАН Вадим Маркович Говорун.
Наша миссия состоит в поиске ответов на фундаментальные вопросы о системной организации биологических систем в норме и при патологии и использовании этих знаний в интересах здоровья и благополучия граждан Российской Федерации. Учреждению также поручено научно-методическое обеспечение деятельности Роспотребнадзора в сфере обеспечения санитарно-эпидемиологического благополучия населения страны.
Сводная информация
- Полное название
-
ФЕДЕРАЛЬНОЕ БЮДЖЕТНОЕ УЧРЕЖДЕНИЕ НАУКИ "НАУЧНО-ИССЛЕДОВАТЕЛЬСКИЙ ИНСТИТУТ СИСТЕМНОЙ БИОЛОГИИ И МЕДИЦИНЫ" ФЕДЕРАЛЬНОЙ СЛУЖБЫ ПО НАДЗОРУ В СФЕРЕ ЗАЩИТЫ ПРАВ ПОТРЕБИТЕЛЕЙ И БЛАГОПОЛУЧИЯ ЧЕЛОВЕКА—
- Короткое название
-
ФБУН НИИ СБМ Роспотребнадзора—
- Тип
- Научно-исследовательский институт